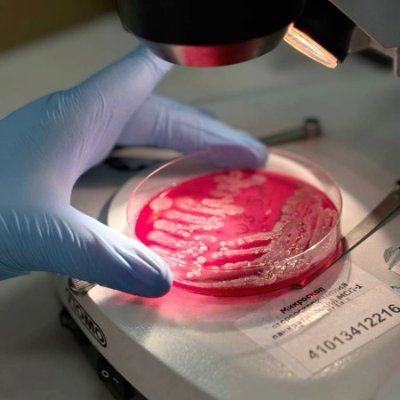
Kokos_Lab_'s profile picture. ✎ᝰ.ᐟ𝗖𝗮𝗻 𝘆𝗼𝘂 𝘀𝗮𝘃𝗲 𝘁𝗵𝗲𝗺 𝗮𝗹𝗹? ⎚-⎚:•.

ﮩ٨ـﮩﮩ٨ـ♡ﮩ٨ـﮩﮩ٨ـ

 - Read extended bio please! -
 - Muse info in pin -
- no emoji means Koko is talking -

The Foundation
@RealMapBot
We are always watching. Read extended bio please. (Owner is @404NeverFind) https://scp-wiki.wikidot.com RP account.
[Temp pin] This is an SCP account. It has its own canon/universe. SCP are called Anomalies and, if human, by name. SCP: SL is technically part of the canon/universe. That's all for now!
//Fundus. No explanation needed. youtube.com/watch?v=rY-FJv…

youtube.com
YouTube
Kero Kero Bonito - Flamingo
⠀ ⠀ ⠀〔.ᐣ.ᐣ.ᐣ〕⠀┄┈⠀QUESTION⠀OF⠀THE⠀DAY⠀.ᐣ ⠀⠀⠀⠀⠀⠀⠀⠀⠀⠀⠀⠀ 〔 #OCRP 〕 ⠀⠀ What song best resonates with your OC .ᐣ ⠀ ⠀
🎭 Hey... why don't you let me join you? I think I'll be able to help you against the Foundation.
(🚨) " Yeah- they're our only nemesis, the UNGOC isn't even something we worry about. "
🦩-? We'll talk once I get out of here!
Attention, all personnel. The head of the Ethics Comittee has been reported missing. If you know anything, please report it to your site director.
🦩-A One week, fuckers... youtube.com/watch?v=lHwlKx…

youtube.com
YouTube
SCP-1507 Theme | SCP: Secret Laboratory OST
🔪 Thank you for letting me stay. 👁️ And for taking care of her. Now, I believe it is time to go. May we see each other again. *Adn they leave.*
"perfect, thank you very much" "And thank you Noko, it was lovely having you here"
Thank you for your submission

👁️ Will do, Map Bot will bring it in a few days or so. 🔪 How do you have so much money? 👁️ Not gonna answer that.
👁️ How much would you like? *He says, without hesitation.*
🎭 Why would I do that? I know that you also "Hate" The Foundation. There is no reason for me to threaten you.
(🚨) " Tttthanks...? Usually, the response is someone pulls out a gun or threatens me something. "
👁️ So, name your "Price", and I'll see what I can do...
👁️ Okay then. However, the work you put in for the pills does need to be paid. So-
"I wouldnt have even met her if it wasnt for Mush, I insist its all perfectly alright"
👁 I insist! You've kept my daughter safe. My daughter, who I thought was dead for 7 years...
"what? no no, theres no need for a repayment" "Im a doctor, its what I do, I help people" - he chuckles a bit -
👁️ Oh, sorry. This must be awkward right? Anyway. Thank you very much of taking care of Noko these past few months. How may I repay the favor, so to speak? *He adjusts his tie a bit.*
- rubbing the back of his neck, not sure what to do in a situation like this - "no.. no issues at all"
United States Trends
- 1. Luka 63.6K posts
- 2. Clippers 18.3K posts
- 3. Lakers 49.3K posts
- 4. Happy Thanksgiving Eve N/A
- 5. #DWTS 95.9K posts
- 6. Good Wednesday 18.6K posts
- 7. #LakeShow 3,553 posts
- 8. Jaxson Hayes 2,500 posts
- 9. Kris Dunn 2,701 posts
- 10. Collar 45.9K posts
- 11. Kawhi 6,349 posts
- 12. Robert 139K posts
- 13. Reaves 12.7K posts
- 14. Jordan 116K posts
- 15. Alix 15.2K posts
- 16. TOP CALL 14.5K posts
- 17. Elaine 46.3K posts
- 18. Colorado State 2,495 posts
- 19. Zubac 2,304 posts
- 20. Shirt 74.2K posts
Something went wrong.
Something went wrong.